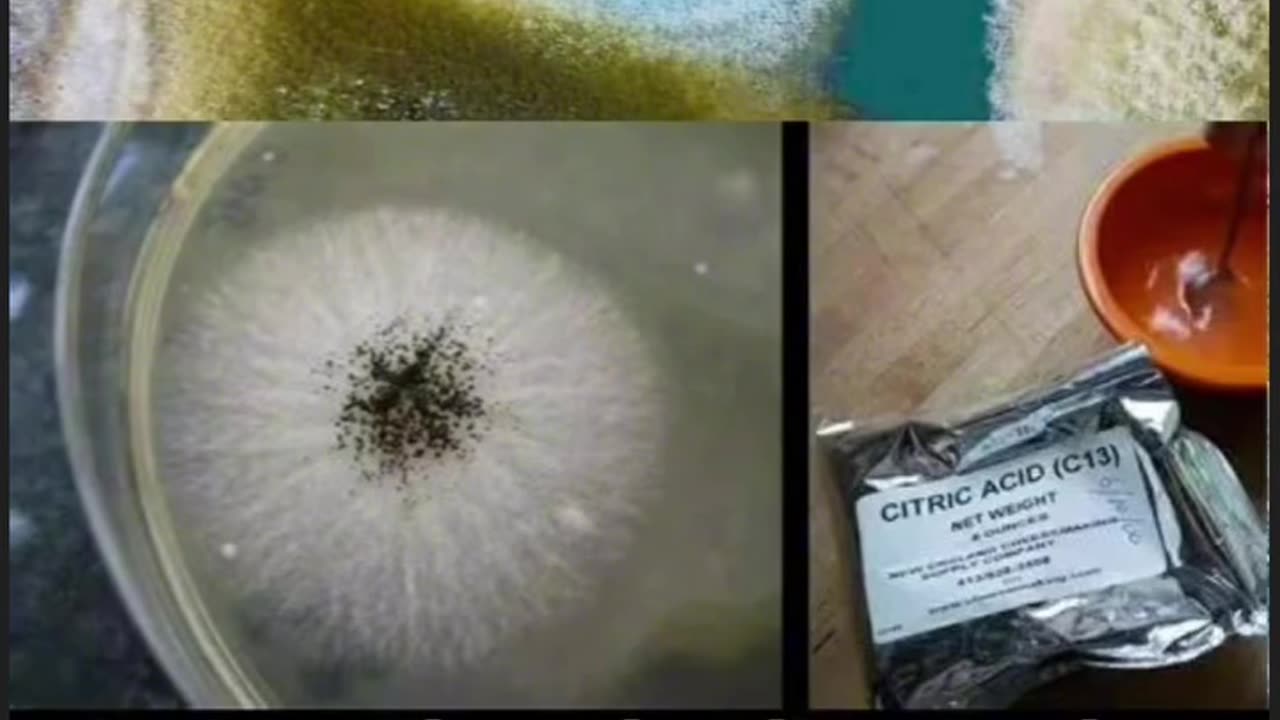

Premium Only Content
This video is only available to Rumble Premium subscribers. Subscribe to
enjoy exclusive content and ad-free viewing.
What really is "Citric Acid", is it mold?
5 months ago
40
Health & Science
Health & Fitness
parasites
doctors
health
anti parasite meds
vaccine
election
law
democrats
conspiracy
YES!!
Loading 1 comment...
-
LIVE
The HotSeat
1 hour agoCommander In Chief and SECWAR Address The Troops, and I AM HERE FOR IT!
829 watching -
LIVE
The Nunn Report - w/ Dan Nunn
1 hour ago[Ep 759] Resist Digital ID | Dems to Shut Down Gov | Obama Library Funds Tides / Terrorists
105 watching -
1:42:33
The Quartering
4 hours agoFat Soldiers BLASTED, Kirk Assassin In Court, JK Rowling Destroys Emma Watson & Crowder Takes Risk
99K13 -
1:17:12
Winston Marshall
3 hours agoExposing The EU’s Plot To Destroy Free Speech in America | Mike Benz
29.6K16 -
1:32:25
Sean Unpaved
4 hours agoMNF Mayhem: Doubleheader Drama, Cheetah's Crushing Fall, & MLB's October Ignition
37.9K1 -
7:07
Michael Heaver
3 hours agoBroken UK Uncovers HORRIFYING Truth
3.96K2 -
2:11:32
Russell Brand
3 hours agoGavin de Becker | Fear, Freedom & Resisting Control - SF642
169K16 -
10:34
Clownfish TV
5 hours agoGetting 'Canceled by Trump' is GREAT for Ratings?! | Clownfish TV
12.4K9 -
14:42
Professor Gerdes Explains 🇺🇦
3 hours agoThis ONE SENTENCE from Putin Guarantees a Long War
10.6K4 -
19:05
Sponsored By Jesus Podcast
2 days agoI Lost the World But Gained My SOUL | Freedom in Christian Suffering
19.5K4